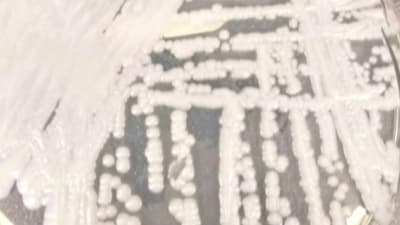

Candida auris

Fact Sheets Candida Auris Fungal Diseases Cdc


Candida Auris The New Superbug On The Block Bbc News
_2.jpg)
What Makes Candida Auris A Super Fungus Nature Portfolio Microbiology Community

Zmwn6hpurgd2fm
Qz9vmerstoy10m

Addressing C Auris And The Looming Fungal Crisis Stat
Candida Auris Epidemiology Biology Antifungal Resistance And Virulence Plos Pathogens

Candida Auris Mannans And Pathogen Host Interplay Trends In Microbiology

Candida Auris A Review Of The Literature Clinical Microbiology Reviews

Candida Auris A Drug Resistant Germ That Spreads In Healthcare Facilities Candida Auris Fungal Diseases Cdc

Candida Auris Resistent Und Renitent Doccheck

Killerpilz Candida Auris Gibt Ratsel Auf Was Steckt Dahinter

Candida Auris Infection

Jof Free Full Text Melanization Of Candida Auris Is Associated With Alteration Of Extracellular Ph

Microorganisms Free Full Text What Do We Know About Candida Auris State Of The Art Knowledge Gaps And Future Directions

Lebensgefahrliche Symptome Durch Den Hefepilz Candida Auris

Global Distribution Of Candida Auris Clades A Phylogenetic Tree Of Download Scientific Diagram

Hxftqy9pyecewm